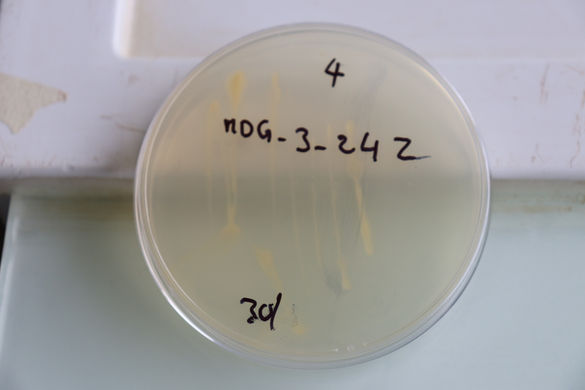
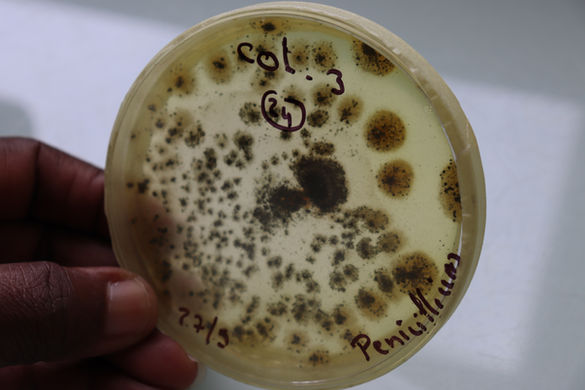
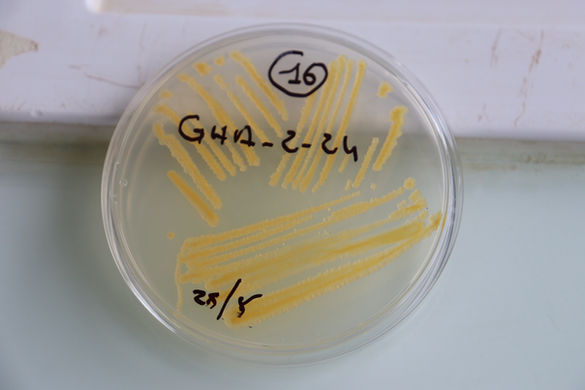

Providing Phytosanitary Services to Agricultural Programs


Our Mission
Deliver sufficiently healthy seed to partners by developing methods for seed health testing that are internationally recognized as reference methods
Our Vision
Safeguard Plant Health and Biodiversity in accordance with FAO and IPPC procedures
Co-Value
Honest - Integrity - Hard Work - Trustworthy
Welcome, we are Germplasm Health
Germplasm health unit (GHU) provide phytosanitary services to four programs at AfricaRice : Genetic Diversity and improvement, Sustainable Productivity Enhancement, Rice Sector Development and Policy, Innovation and Impact Ass. All of these programs play a critical role in providing disease-free seeds to seed systems for multiplication and distribution to farmers. GHU makes sure that no pests of quarantine importance in Cote d’Ivoire are present in the materials handled and exchanged by these programs.



OURS PARTNERS